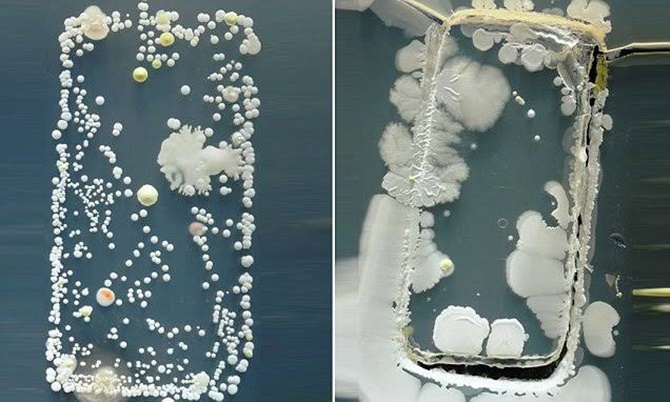

Hindari Virus dan Bakteri, Samsung Umumkan Program Sanitasi Smartphone
Photo
JawaPos.com - Smartphone saat ini tak bisa lepas dari genggaman. Oleh karenanya, di tengah wabah virus korona COVID-19 yang marak belakangan ini, smartphone bisa menjadi salah satu media penularan infeksi. Lantaran menjadi tempat yang terbilang kotor.
Sebagai upaya meredam dampak virus korona atau COVID-19 yang melanda banyak negara, Samsung mengumumkan program sanitasi atau pembersihan smartphone. Diinformasikan di laman resminya, Samsung menggelar program ini di 19 negara yang menjadi pasar strategis mereka.
Konsumen yang datang dengan perangkat yang membutuhkan perbaikan, tim di pusat layanan akan membersihkannya juga dengan sinar UV. Layanan ini gratis dan menggunakan lampu UV-C untuk menjaga perangkat konsumen bersih tanpa menggunakan bahan kimia yang keras. Dan itu juga tidak akan merusak perangkat, berdasarkan pengujian yang cermat dari Samsung.
Tak hanya merek ponsel Samsung, konsumen bahkan diizinkan untuk dapat membawa ponsel non-Samsung, pusat layanan akan tetap membersihkannya secara gratis. Hanya perlu 30 detik untuk membunuh 99,9 persen kuman di perangkat.
Sementara itu, untuk beberapa perangkat lain semisal tablet dan smartwatch, pembersihan dilakukan secara khusus. Yakni dibawa ke tempay khusus berdasarkan regional masing-masing.
Berikut adalah negara-negara di mana Samsung menawarkan Layanan Sanitasi Galaxy: Argentina, Chili, Kroasia, Denmark, Finlandia, Jepang, Republik Korea, Malaysia, Selandia Baru, Norwegia, Pakistan, Peru, Polandia, Rusia, Spanyol, Swedia, Amerika Serikat, Ukraina, dan Vietnam.
Itu hanya gelombang pertama, layanan serupa akan segera tersedia di Australia, Austria, Kanada, Ceko, Prancis, Yunani, Hong Kong, Hongaria, India, Indonesia, Israel, Italia, Yordania, Kazakhstan, Latvia, Meksiko, Belanda, Panama, Filipina, Rumania, Singapura, Taiwan, Thailand, Uni Emirat Arab, dan Inggris.
Saksikan video menarik berikut ini:
https://www.youtube.com/watch?v=yNnCfdqZVKA
https://www.youtube.com/watch?v=0SinELPXYC8
https://www.youtube.com/watch?v=HhZjge6lJ78
Tags
Artikel Terkait
Terpopuler

Dana Desa Terpangkas untuk Koperasi Merah Putih, Pembangunan Infrastruktur Sebagian Desa di Tulungagung Tak Sesuai Rencana
50 Unit Mobil Koperasi Desa Merah Putih Tiba di Wonogiri, Dandim 0728/Wonogiri: Saran Saya Tidak Usah Digunakan Dulu Mobilnya
12 Spot Kuliner Bakso di Bandung yang Terkenal karena Tekstur Dagingnya yang Juara
15 Rekomendasi Restoran Terbaik Dekat Tugu Muda Semarang: Surganya Kuliner yang Wajib Dicoba Pelancong dan Wisatawan!
18 Rekomendasi Sarapan Pagi di Bandung Paling Sedap, Sederet Kuliner Mantap yang Wajid Disantap
Kabar Gembira! Gubernur Banten Resmi Hapus Pajak Kendaraan Bermotor, Ini Syaratnya!
10 Spot Mie Kocok di Bandung Terenak, Kuliner Khas dengan Kuah Kental dan Bumbu Tradisional
12 Restoran Seafood Terenak di Bandung, Surganya Kuliner Laut yang Tak Pernah Sepi Pengunjung
15 Kuliner Bakso di Solo yang Selalu Jadi Incaran, dari yang Paling Legend hingga yang Kekinian
Jadwal Thomas Cup 2026 Indonesia vs Aljazair, Siaran Langsung, dan Live Streaming: Laga Perdana Wajib Menang!

- Nasional
- Haji
- Ekonomi
- Oto Dan Tekno
- Arsitektur Dan Desain
- Jawa Pos 75 Tahun
- Kabinet Merah Putih
- Features
- Jabodetabek
- Humaniora
- Islami
- Hobi & Kesenangan
- Sports
- Infrastruktur
- Zodiak
- Kepribadian
- Berita Daerah
- Entertainment
- Lifestyle
- Internasional
- Kesehatan
- Sepak Bola Indonesia
- Opini
- Surabaya Raya
- Sisi Lain
- Ternyata Hoax
- Sepak Bola Dunia
- Minggu
- Art Space
- Parenting
- Kuliner
- Karir


